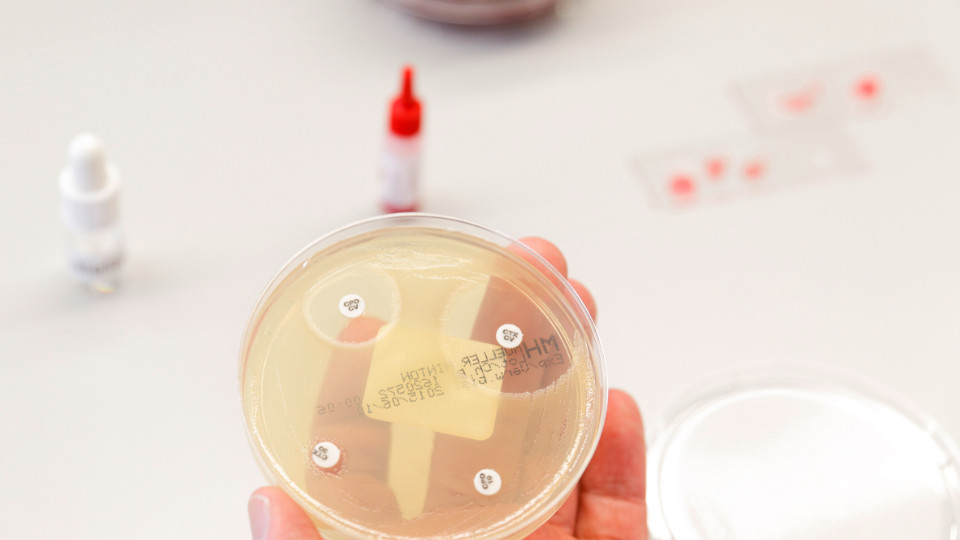
Jenaer Standards werden bundesweite Leitlinie

Gemeinsam auf Mission Fusarium
Sie sind gefürchtete Krankheitserreger und Hoffnungsträger zugleich: Pilze der Gattung Fusarium. Weltweit auf dem Vormarsch können sie lebensbedrohliche Infektionen hervorrufen. Gleichzeitig bergen die von ihnen produzierten Naturstoffe eine bisher kaum erschlossene Quelle für neue Antiinfektiva. Dieser doppelten Herausforderung stellt sich das neue Forschungsprojekt FUSION am Leibniz-HKI, das genetische Pilzforschung mit robotikgestützter Wirkstoffsuche verbindet. FUSION eröffnet durch die Kombination aus genetischer Analyse, mikrobiologischer und chemischer Expertise sowie automatisierten Screening-Verfahren neue Möglichkeiten. So lassen sich unterschiedliche Kultivierungsbedingungen systematisch vergleichen oder neue Pilzisolate untersuchen – etwa aus der Umgebung Thüringens.
Foto: Leibniz-HKI

Klarer Himmel